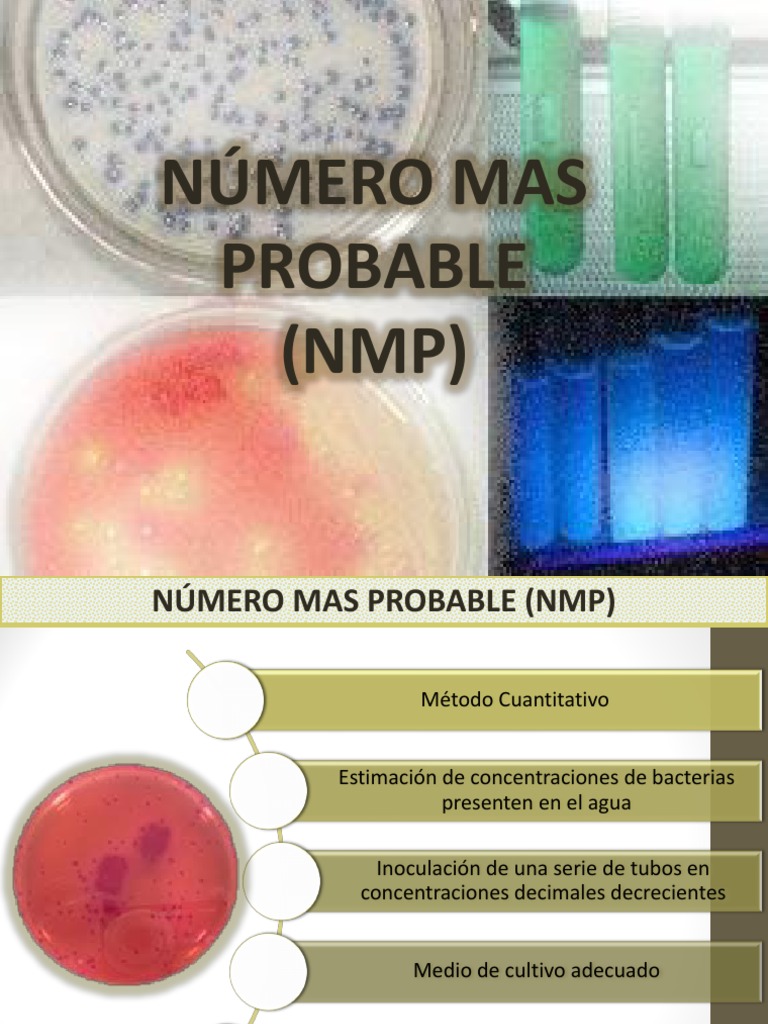
Numero Mas Probable PDF Patologia clinica Microbiología

El método del Número más probable (NMP) (Most probable number - MPN - en inglés) es una forma de obtener datos cuantitativos a partir de datos de presencia o ausencia (positivo/negativo). Es una estrategia eficiente para estimar densidades de población.
Descripción
El método se basa en determinar la presencia o ausencia (positivo o negativo) de determinados microorganismos en muestras obtenidas por diluciones seriadas consecutivas a partir de muestras de comida u otros ambientes. Se basa en el principio de que una única célula viva puede desarrollarse, evolucionar y producir toda una colonia que se vería como una turbidez en el cultivo. El método requiere la realización de diluciones en serie de la muestra de cultivo, en un medio de cultivo adecuado para el crecimiento de dicho organismo. Luego, se incuban las muestras de esos tubos y, pasado un día, se examinan los tubos. Aquellos tubos que recibieron una o más células microbianas procedentes de la muestra, se pondrán turbios, mientras que los tubos que no recibieron ninguna célula permanecerán sin cambios.
Al aumentar el factor de dilución seriada, se consigue que algunos tubos solo contengan cien microorganismos y otros tubos contengan un millón. Al calcular la probabilidad de que los tubos no hayan recibido ninguna célula, se puede estimar el número más probable de microorganismos presentes en la muestra original, a partir de una tabla estadística.[1]
La precisión del método del número más probable aumenta con el número de tubos que se usan; cinco tubos por dilución se considera como una relación adecuada entre precisión y economía.
Una condición del método es la necesidad de poder reconocer un atributo específico de la población en el medio de crecimiento que se emplee. La estimación de la densidad poblacional se obtiene del patrón de ocurrencia de ese atributo en sucesivas diluciones en serie y el empleo del cálculo probabilístico.[2]
Hay muchas entidades discretas que son fáciles de detectar pero difíciles de contar. Una aplicación es la de cualquier clase de reacción de amplificación o reacción de catálisis que impide una cuantificación fácil, pero permite que su presencia sea detectada de modo muy sensible. Algunos ejemplos comunes son: crecimiento de microorganismos, acción enzimática, o catálisis química. El método del NMP supone tomar la disolución original o muestra y diluirla.
El grado de dilución para el cual comienza a aparecer la ausencia indica que los elementos se han diluido tanto que hay muchas submuestras en las que no aparece. Un juego de repeticiones para cualquier concentración dada permite una resolución más fina, para usar el número de muestras positivas y negativas que estiman la concentración original dentro del apropiado orden de magnitud.
Aplicaciones
Este método se usa para contar microorganismos difíciles de cultivar en medio sólido, o para determinar el número de células que pueden crecer en un medio líquido determinado, como el análisis para determinar la contaminación del agua potable, determinando el número de bacterias Escherichia coli que pueden crecer en un medio con lactosa. La presencia de E. coli en el agua potable es una prueba de contaminación.
En microbiología, el método se emplea habitualmente realizando diluciones en serie de un cultivo de bacterias en un medio de crecimiento, y luego divisiones adicionales en serie hasta obtener partes alícuotas. Los cultivos son incubados y evaluados a ojo, eludiendo el tedioso recuento de colonias, o el caro y tedioso recuento microscópico.
En biología molecular, una aplicación habitual se da en las plantillas de ADN diluidas para la reacción en cadena de la polimerasa (PCR).
Las reacciones sólo se dan si una plantilla está presente, permitiendo una forma de PCR cuantitativa, para así evaluar la concentración original de las moléculas de la plantilla. Otra aplicación consiste en diluir los depósitos de enzima en la disolución que contiene un sustrato cromogénico, o diluir antígenos en disoluciones para ensayos ELISA (Enzyme-Linked ImmunoSorbent Assay) o alguna otra reacción de detección en cascada de anticuerpos, para medir la concentración original de enzima o de antígeno.
La principal debilidad de los métodos del número más probable es la necesidad de un gran número de copias duplicadas con la dilución adecuada para estrechar los intervalos de confianza. Sin embargo, es un método muy importante para recuento cuando el orden de magnitud es desconocido a priori y el muestreo es necesariamente destructivo.
Véase también
- Dilución en serie
Enlaces externos
- A downloadable MPN calculator to take your data and get estimates (en inglés)
- A five-replicate MPN table (en inglés)
- Details of practical implementation, but not theory (en inglés)
Referencias
- Oblinger, J.L., and J. A. Koburger, J.A. (1975) "Understanding and Teaching the Most Probable Number Technique." J. Milk Food Technol. 38(9), 540–545.
..